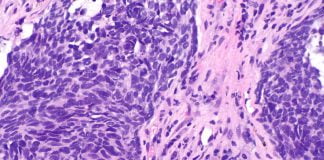
Cancerul pulmonar – cauze si tratament Cancerul pulmonar - cauze si tratament

Boli ale nasului care survin in timpul iernii dupa o raceala
Datorita frigului raceala este o boala care apare mai mult iarna si mai putin in alte anotimpuri. La fel de frecvente sau mai putin...
Care este diferenta dintre gripa si raceala?
De cele mai multe ori suntem tentati sa numim o forma moderata de gripa ca fiind o raceala si invers. Pur si simplu ne...
Ce este gripa?
Ce este gripa? – Specialistii considera ca ar fi una dintre cele mai periculoase si dificile boli infectioase si acest lucru se datoreaza faptului...
Migrena, o boala neurologica care se poate trata cu plante medicinale
Una dintre bolile cele mai comune ale sistemului nervos este migrena – care se manifesta prin frecvente dureri de cap cauzate de anumiti factori...
Top 10 cele mai periculoase boli
Care sunt top 10 cele mai periculoase boli din lume? Daca toti trecem prin probleme de sanatate periodic si le tratam, trebuie sa aflam...
Terapia cu lumina ultravioleta (terapia fotoluminiscenta)
Lumina ultravioleta a fost descoperita de catre fizicianul german Johann Wilhelm Ritter, in anul 1801. La sfarsitul secolului al XIX-lea, cercetatorii au inceput sa...
Top 10 sfaturi babesti pentru o sanatate mai buna
Daca nu va simtiti bine si medicamentele obisnuite nu par a va face prea mult bine, incercati unul dintre sfaturile din top 10 sfaturi...
Terapia cu oxigen – o metoda controversata
Terapia cu oxigen (oxigenoterapia) nu este o practica medicala recenta, nici o descoperire senzationala, cum ar putea parea, avand in vedere interesul crescut, manifestat,...
Top 10 cele mai ciudate boli din lume
In top 10 cele mai ciudate boli se afla sindromul francezului saltaret, o boala manifestata la taietorii de lemne francezi din regiunea Maine, de...
Top 10 cele mai consumate medicamente de romani
Stim ca romanii consuma pumni intregi de pastile zilnic, insa care remedii se afla in top 10 cele mai consumate medicamente de romani? De...
Artrita psoriazica – cauze si tratament
Artrita psoriazica reprezinta o boala autoimuna ce afecteaza ligamentele, tendoanele, articulatiile si fascii si poate aparea si in lipsa componentelor tegumentare. Boala este caracterizata...
Cancerul pulmonar – cauze si tratament
Cancerul pulmonar reprezinta una dintre cele mai comune cauze de deces datorate tumorilor, efectul sau negativ fiind depasit doar de cancerul mamar si cel...
Cancerul pancreatic – cauze si tratament
Cancerul pancreatic nu se afla in cele mai frecvente 10 tipuri de cancer, insa reprezinta unul dintre cele mai mortale tipuri de cancer din...
Care sunt simptomele infectiilor cu bacteria Salmonella si cum pot fi...
Toxiinfectiile alimentare cu bacteria Salmonella sunt unele dintre cele mai des intalnite afectiuni (mai ales in timpul verii) si sunt legate de produse contaminate...
Cancerul de piele – cauzele si tratamentul melanomului
Cancerul de piele, cunoscut si sub numele de melanom, reprezinta forma de cancer cutanat ce debuteaza la nivelul celulelor producatoare de pigment. Melanocitele, caci...